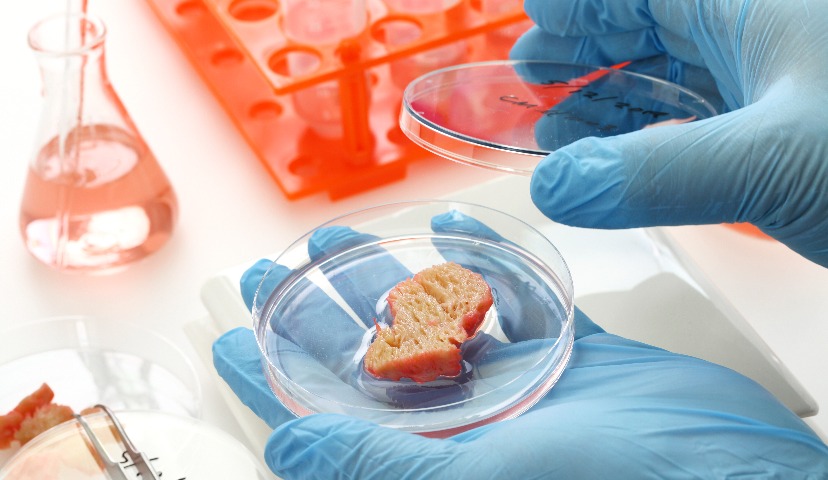
Искусственное или настоящее? Что есть мясо в 2020?

Искусственное или настоящее? Что есть мясо в 2020?
В последнее время, в том числе на волне интереса к вегетарианству и разговорам про грядущую нехватку продовольствия в связи с ростом численности мирового населения, появляется все больше новостей про «искусственное мясо», «выращенное мясо», «мясо из пробирки», «культивируемое мясо», «растительное мясо».
Есть ли разница между этими понятиями? Какой продукт может называться мясом, а какой – нет? Давайте разбираться.
«Искусственное мясо, выращенное мясо, мясо из пробирки, культивируемое мясо – все это определения для продукта, полученного в лабораторных условиях, – объясняет Валентина Перегудова, главный технолог Наро-Фоминского мясокомбината. – По своей сути он представляет собой полноценный мышечный белок, который пока, правда, не выстраивается в мышечное волокно, а растет на питательной среде хаотично. Таким образом, продукт больше напоминает фарш, чем структурированное мясо».
Растительным мясом, по ее словам, называют продукт из растительного белка, но по внешним органолептическим признакам определяющейся как мясо. То есть, он может иметь вкус мяса, запах мяса, цвет мяса, даже консистенцию мяса, однако не содержать в своем составе животных компонентов.
«С моей точки зрения есть две глобальных категории, которые мясом не являются, – говорит Роман Калинин, директор отраслевого агентства для пищевой промышленности «Ватель Маркетинг». – К первой относится «псевдомясо» – суррогат, сделанный из растительного сырья: сои, смесей, нута, маша с ароматикой мяса. Вторая категория – субстанция, выращенная из мясных клеток. У первого продукта будет ДНК растительного сырья, у второго – ДНК животного сырья».
По его убеждению, когда мы вводим в состав мясного продукта какую-либо замену мяса, то это продукт не мясной, а мясосодержащий. По аналогии с молоком: колбаса может быть мясная и «мясосодержащая». И, конечно, подчеркивает Роман Калинин, должен быть определен минимальный процент мяса в продукте, чтобы он оставался «мясным».
Согласно нормативному определению, которое приводит Валентина Перегудова, мясо – это мышечная ткань с прилегающей к ней соединительной, жировой и костной тканью (для мясокостного продукта; без кости – для мякотного). Кроме того, каждая из тканей имеет свою характерную структуру.
«Исходя из этого, то, что сейчас позиционируется как альтернатива или замена мяса, не может называться мясом в полной мере, – рассуждает она. – Для мяса “из пробирки” больше подошло бы название “продукт из мышечного белка”. Соответственно, для растительного мяса – “продукт из растительного белка” (с уточнением природы белка – соя, горох и т.д.)».
Кстати, несколько российских мясокомбинатов разработали и запустили новинки с заменой натурального мяса на альтернативное.
Стремясь соответствовать запросам потребителей, но при этом не желая вводить их в заблуждение, Наро-Фоминский мясокомбинат разработал линейку продукции, которая выпускается под брендом «НЕМЯСО». В линейку входят колбасы, сосиски, полуфабрикаты на растительной основе. Продукт, как заявляет производитель, подходит для вегетарианского и постного стола.
Другой важный вопрос – могут ли альтернативные продукты обладать такой же питательной ценностью как мясо?
«Полный набор незаменимых аминокислот содержится только в натуральном мясе. Заменить их растительным сырьем в полной мере невозможно!» – утверждает Роман Калинин.
С ним полностью согласна Валентина Перегудова.
«Если говорить о растительном продукте, то давно известно, что соевый белок имеет пищевую ценность, близкую к белку мяса, однако, все-таки, уступает ему. Поэтому продукт на основе растительного белка вряд ли будет иметь такую же питательную ценность, как мясо», – подтверждает она.
А вот мясо «из пробирки», по мнению Валентины Перегудовой, вполне может не просто догнать мясо, но и иметь более высокую питательную ценность.
«Здесь дело только во времени, в темпах развития науки в данном направлении, – считает она. – Теоретически можно создать легкоусвояемый, высокопитательный полноценный продукт. Другой вопрос, как понять, насколько безопасно это “мясо будущего”?»
Свое мнение по данному вопросу высказал генеральный директор Группы «Черкизово» Сергей Михайлов.
«Есть два направления – выращивание животных клеток в питательной среде и производство растительных имитаций мяса. И если в первом случае до коммерческого продукта еще далеко, то “растительные бургеры” уже появилось в России, – говорит Сергей Михайлов. – Но будем осторожны с терминологией – это не ”искусственное мясо”, а искусственная еда, состоящая из более, чем 20 компонентов. Ее основу – изоляты растительного белка – можно купить в магазинах спортивного питания».
Как подчеркивает Сергей Михайлов, заслуга производителей «невозможных» и «запредельных» растительных «котлет» заключается в том, что они научились разводить эти порошки рапсовым и кокосовым маслом так, что это напоминает нормальный мясной полуфабрикат, но по цене значительно превышает натуральные аналоги.
«В достижении вкусового сходства им помогает десяток загустителей, ароматизаторов и изрядная порция соли. Затем эта субстанция позиционируется как заменитель мяса», – объясняет генеральный директор Группы «Черкизово».
Кстати, недавно стало известно, что ресторанные и торговые сети в России начали предлагать растительное мясо американского производителя Beyond Meat, созданное на основе горохового белка.
С точки зрения Романа Калинина, сегодня в России это бесперспективное направление. Он полагает, что в массовом ритейле такой продукт не будет продаваться. Шанс на успех у него есть в особых, авторских ресторанах внутри Садового кольца.
«Растительное мясо может пользоваться спросом в России как сегментарный, нишевой продукт, – продолжает Роман Калинин. – Также как пользуется спросом печенье из амарантовой муки, шоколад без сахара и хлеб без глютена. У всех этих продуктов, безусловно, есть свои покупатели. Но по отношению к общему объему потребления такой продукции (хлеба, молока, шоколада) – это доли процента».
Он добавляет, что на сегодняшний день основные перспективы лежат в зоне стартапов и венчурных инвестиций, поскольку это товарная категория, где интересно создавать новое и инвестировать.
«Однако я смотрю со скепсисом на то, что альтернативное мясо в ближайшем будущем займет существенную часть от общего потребления мяса натурального», – подчеркивает Роман Калинин.
«Основная масса населения, конечно, не готова принять этот продукт в контексте замены мяса, – соглашается Валентина Перегудова. – Количество веганов и вегетарианцев в России не превышает 2%. Пока, по моему мнению, «растительное мясо» может, скорее, выступать как сопутствующий продукт в рационе питании россиян. А из-за высокой цены он будет еще и не по карману для большей части населения».
Однако Валентина Перегудова отмечает, что если посмотреть с перспективой на будущее, принять во внимание глобальные проблемы человечества (увеличение численности населения, голод, нехватка ресурсов) – этот продукт имеет шанс на жизнь.
«При этом такие продукты, в первую очередь должны позиционироваться не с точки сопоставления с мясом, – обращает внимание Валентина Перегудова. – Это, скорее, продукт функциональной направленности. Ни в коем случае с помощью данных новинок нельзя укреплять негативное отношение к мясу и мясопродуктам!».
Она напоминает, что питание здорового человека должно быть и разнообразно, и полноценно!
«Сегодня мясопереработчикам самим нужно говорить про ЗОЖ, диету, осознанное и рациональное потребление. Нужно задуматься о формировании у целевой аудитории потребительских трендов, как это делают молочники, а не следовать им», – добавляет Роман Калинин.
«Полезен ли такой продукт для здоровья? – задает главный вопрос Сергей Михайлов. – Это, мягко говоря, не доказано. Диета должна быть сбалансированной. Нельзя в погоне за дополнительной прибылью пытаться вытеснить из рациона продукты животного происхождения, играя на страхе потребителя и его желании сделать мир лучше».
Он подчеркивает, что пока в Группе «Черкизово» не видят достойной замены мясу животных, и в обозримом будущем, уверен Сергей Михайлов, оно будет основой нашего питания.
СПРАВКА
Структура выброса парниковых газов в США:
- транспорт – 29%;
- выработка электричества – 28%;
- промышленность – 22%;
- жилье и торговые помещения – 12%;
- сельское хозяйство – 9%.
Источник: United States Environmental Protection Agency
Автор материала – Ирина Правская, руководитель направления разработки «Константа ИТ» Материал подготовлен совместно с партнером комьюнити по...
В пятницу, 20 марта 2026 года прошел форум АПК 360, где принимало участие много именитых и известных отраслевых деятелей и...
Материал подготовлен совместно с комьюнити Digital4food и Ириной Правской, руководителем направления разработки «Константа ИТ» И вот момент...
Парейдолия - это распространенная зрительная иллюзия, при которой мозг, стремясь распознать знакомые образы, «дорисовывает» базовые...
Новинки Останкино (ТМ "Папа Может", "Останкино", "Коровино") на выставке ПРОДЭКСПО 2026 ...
Коллеги цифровизаторы-интеграторы, айтишники и все умеющие отличать штрих-коды от...
Уважаемые коллеги здравствуйте. скажите пожалуйста кто уже подал заявку на участие в пилотном...
ну или креазот и деготь вам на стол для вашей печени. Фото снято в ноябре 2025...
Здравствуйте. Остаётся щетина после обесволашивания. Пробовали увеличение циклов, замену бил,...
Здравствуйте, уважаемые! Посоветуйте, пожалуйста. Предлагают по 80000 рублей две термокамеры...
Добрый вечер всем. Когда то писал письмо в ВНИИМП по данным книгам, которые они издавали, на...
















Жаль, что мы не дождались ответов нескольких компаний, кто занимается разработками по культивации мяса. Думаю, что будущем у нас выйдут совместные материалы.